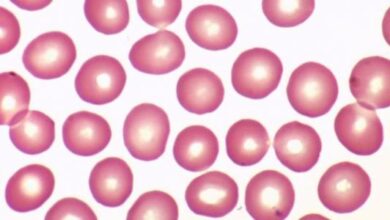

محتويات

في الحقيقة يتم إنتاج خلايا الدم الحمراء في الجسم بشكل مستمر من الخلايا الجذعية في نخاع العظم (نسيج اسفنجي يوجد داخل بعض العظام في الجسم)؛ وذلك بتحفيز من هرمون الإريثروبيوتين (بالإنجليزية: Erythropoietin) الذي تفرزه الكلى، وإضافة لهذا الهرمون يحتاج الجسم مواداً إضافية لإنتاج خلايا الدم الحمراء السليمة وتتضمن: الحديد، وفيتامين ب 12، والفوليك أسيد (بالإنجليزية: Folate)، وتعمل خلايا الدم الحمراء بشكل أساسي على حمل الأكسجين ونقله إلى أجزاء الجسم المختلفة، وتعيش خلية الدم الحمراء الواحدة لمدة تصل إلى 120 يوماً، تتحطم بعدها بشكل طبيعي في الجسم، ويجدر بالذكر أنّه على الرغم من تحطيم الجسم لخلايا الدم الحمراء بعد ما يصل إلى 120 يوماً من إنتاجها إلا أنّه يستفيد من الحديد الموجود في الهيموجلوبين داخل الخلية، ليعيد استخدامه مرة أخرى في تصنيع خلايا دم حمراء جديدة،[١][٢] وبناء على ذلك يمكن القول أنّ أي خلل في إنتاج كريات الدم الحمراء ودورة حياتها قد يؤدي للإصابة بفقر الدم أو الأنيميا (بالإنجليزية: Anemia)، ويمكن تقسيم بشكل عام تقسيم الأسباب والاضطرابات التي تؤدي لفقر الدم إلى ثلاث فئات رئيسية؛ اضطرابات تتسبب بحدوث نقص أو خلل ما في عملية تكوين كريات الدم الحمراء السليمة، أو اضطرابات تزيد معدل تحلل أو تكسر كريات الدم الحمراء، أو المشاكل التي تؤدي لفقدان الدم نتيجة حدوث نزيف.[٣]
يحدث هذا النوع من فقر الدم عندما لا يتمكن الجسم من إنتاج عدد كافٍ من كريات الدم الحمراء السليمة والقادرة على العمل بكفاءة، ويمكن بيان الحالات والاضطرابات الصحية التي تُسبّب هذا النوع من فقر الدم كما يأتي:[٣]
يُعدّ فقر الدم الناتج عن نقص الحديد (بالإنجليزية: Iron deficiency anemia) أكثر أنواع فقر الدم شيوعًا، ويحدث في حال وجود نقص في عنصر الحديد الضروري لتكوين جزيء الهيموغلوبين الموجود في كريات الدم الحمراء، وينشأ نقص الحديد في الجسم عن عدم الحصول على كمية كافية من الحديد عبر النظام الغذائي، وفيما يلي بيان لمجموعة من الأسباب التي يمكن أن تؤدي إلى ذلك:[٣][٤]
- اتباع نظام غذائي فقير بالحديد ولا يزوّد الجسم بحاجته منه، ومن الأمثلة على الأطعمة الغنية بالحديد: اللحوم، والبيض، والخضراوات الورقية الخضراء.
- سوء امتصاص الحديد من الطعام؛ كما في حال الإصابة ببعض الأمراض والاضطرابات التي تصيب الجهاز الهضمي وتخلّ في قدرته على امتصاص بعض المواد الغذائية بما في ذلك عنصر الحديد مثل؛ داء سيليلاك (بالإنجليزية: Celiac disease) المعروف بين الناس بمرض حساسية القمح وداء كرون (*) (بالإنجليزية: Crohn’s disease)، ومن الأسباب الأخرى التي يمكن أن تؤدي لسوء امتصاص الحديد: الخضوع لعمليات جراحية تتضمن استئصال جزء كبير من الأمعاء.
- الحمل؛ فدون استخدام المكملات الغذائية التي تحتوي على الحديد قد تتعرض بعض الحوامل للإصابة بفقر الدم، نتيجة لزيادة احتياجات الجسم والجنين للحديد.
- النزيف المزمن والبطيء؛ كما في حالات الإصابة بقرحة المعدة التي يرافقها نزيف، أو الإصابة ببعض السرطانات كسرطان القولون أو سرطان الرحم بالإضافة للنزيف الذي قد يحدث بسبب الإصابة بالبواسير، أو نزيف الطمث الغزير.
يحدث فقر الدم بعوز فيتامين ب 12 (بالإنجليزية: Vitamin B12 deficiency anemia) بسبب انخفاض مستوى فيتامين ب 12 في الجسم عن الحدود الطبيعية، ويُعدّ فيتامين ب 12 من الفيتامينات الضرورية في تكوين كريات الدم الحمراء في الجسم، وفي حالة نقصه لا تنضج خلايا الدم الحمراء بالصورة المناسبة، ويصبح حجمها أكبر من المعدل الطبيعيي، ويحدث هذا الانخفاض نتيجةً لعدة أسباب، منها ما يتعلّق بافتقار النظام الغذائي لفيتامين ب 12، وآخر يتعلّق بوجود بعض الحالات التي تجعل امتصاص فيتامين ب 12 صعبًا، كالإصابة ببعض الاضطرابات الهضمية، أو تناول الكحول، أو إساءة استخدام أكسيد النيتروز (*)، كما قد يحدث بسبب إجراء عملية جراحية لاستئصال جزء من المعدة أو الأمعاء الدقيقة، أو نتيجة تناول أنواع معينة من الأدوية، إضافة إلى الإصابة بفقر الدم الخبيث (بالإنجليزية: Pernicious anemia)؛ الذي يحدث حينما يُدمّر الجسم الخلايا المسؤولة عن إنتاج العامل الداخلي (*) الذي يُعدّ بروتيناً ضرورياً لامتصاص فيتامين ب12.[٥][٦]
يحدث فقر الدم الناجم عن نقص حمض الفوليك (بالإنجليزية: Folate-deficiency anemia) عندما ينخفض مستوى كريات الدم الحمراء نتيجة لافتقار الجسم لكميات كافية من حمض الفوليك، وهو أحد أنواع فيتامين ب الذي يلزم لإنتاج كريات الدم الحمراء، وفيه يصبح حجم كريات الدّم الحمراء أكبر من المعدل الطبيعي، وتجدر الإشارة إلى أنّ نقصان حمض الفوليك في الجسم قد يكون نتيجة لعدة أسباب، منها: افتقار النظام الغذائي لحمض الفوليك، أو تناول بعض أنواع الأدوية، أو تناول الكحول لفترات طويلة، أو بسبب الإصابة بفقر الدم الانحلالي؛ الذي سيتم توضيحه في المقال لاحقًا.[٧]
ولمعرفة المزيد عن أسباب فقر الدم الناجم عن نقص حمض الفوليك يمكن قراءة المقال الآتي: (أسباب فقر الدم بعوز حمض الفوليك).
يُعدّ فقر الدم المنجلي (بالإنجليزية: Sickle Cell Disease)، واختصارًا SCD، أحد اضطرابات كريات الدم الحمراء الوراثية، وفيه تتّخذ كريات الدم الحمراء شكل المنجل أو الهلال، وهو وضع مغاير لشكلها الطبيعي، الذي يُفترض أن يكون على شكل قرص، وذلك نتيجة لتغيّر شكل الهيموجلوبين الناجم عن حدوث خلل جيني في الجسم، مما يؤدي لانخفاض قدرة هذه الكريات المعيبة على حمل الأكسجين، بالإضافة لزيادة صلابتها واختلال مرونتها التي كانت تتيح لها القدرة على المرور عبر الأوعية الدموية الضيقة، ولذلك قد تعلق في الأوعية الدموية أثناء تدفّق الدم، وتؤدي إلى انسدادها كليًّا أو جزئيًّا مسببة بذلك الشعور بالألم بسبب نقصان الأكسجين الواصل للخلايا، كما ينخفض معدل حياة كريات الدم الحمراء في فقر الدم المنجلي ليتراوح ما بين 10-20 يومًا بدلاً من المعدل الطبيعي (90-120 يوماً)، لإضافة إلى أنّ الجسم قد يفشل في تعويض النقص في عدد كريات الدم الحمراء السليمة، فيكون عددها في الجسم غير كافٍ، وبالتالي يحصل فقر الدم.[٣][٨]
قد تؤدي اضطرابات ومشاكل نخاع العظم للإصابة بفقر الدم، وذلك إما بسبب عدم وجود أعداد كافية من الخلايا الجذعية (*) المسؤولة عن تكوين كريات الدم الحمراء، وإما بسبب عدم كفاءة هذه الخلايا في التطور إلى كريات دم حمراء طبيعية، وإما بسبب نمو خلايا سرطانية في نخاع العظم، ويجدر بالذكر أنّ الصفائح الدموية ومعظم أنواع خلايا الدم البيضاء يتم إنتاجها من الخلايا الجذعية في نخاع العظم أيضاً، وبالتالي فإنّ من أنواع فقر الدم الناتج عن اضطرابات نخاع العظم قد يؤدي إلى تدني كفاءة إنتاج كريات الدم البيضاء والصفائح الدموية بالإضافة لكريات الدم الحمراء، أو عدم إنتاجها على الإطلاق ويمكن بيان بعض من أشكال فقر الدم الناجم عن اضطرابات نخاع العظم ما يلي:[٣][٩]
- فقر الدم اللاتنسجي: (بالإنجليزية: Aplastic Anemia) يحدث هذا النوع من فقر الدم في حال تعرض الخلايا الجذعية في نخاع العظم للتلف وبالتالي عدم وجود ما يكفي من الخلايا الجذعية، أو عدم وجودها أصلاً، مما يؤدي إلى عدم إنتاج كميات كافية من كريات الدم الحمراء، والبيضاء، والصفائح الدموية أو عدم إنتاجها على الإطلاق، وعلى الرغم من عدم وجود سبب واضح ومعين يؤدي إلى فقر الدم اللاتنسجي في بعض الأحيان، إلّا أنّه قد ينتج بسبب التعرض لعدة عوامل، مثل: الخضوع للعلاج الكيميائي، أوالتعرّض للإشعاع، أو الإصابة بعدوى ما.
- متلازمة خلل التنسج النخاعي: أو متلازمة خلل التنسج النقوي (بالإنجليزية: Myelodysplastic syndrome)، تختلف هذه الحالة عن فقر الدم اللاتنسجي في أنّها لا تنتج عن نقص الخلايا الجذعية؛ حيث عادة ما يكون لدى المصاب بمتلازمة خلل التنسخ النخاعي عدد كافٍ من الخلايا الجذعية المسؤولة عن تكوين خلايا الدم ولكنّها لا تتطور وتنضج بشكل طبيعي لتكوين خلايا الدم، فينتج عنها خلايا دم معيبة وغير ناضجة بعضها يموت في نخاع العظم، والبعض الآخر الذي ينتقل لنخاع العظم قد لا يعمل بشكل طبيعي ولا يعيش لفترة كافية، ويجدر بالذكر أنّ المصاب بمتلازمة خلل التنسج النخاعي قد يعاني من انخفاض عدد كريات الدم الحمراء، أو البيضاء، أو الصفائح الدموية السليمة أو جميعها معاً.
- التسمّم بالرصاص: يُعدّ الرّصاص مادّة سامّة لنخاع العظم، وفي حال تعرّض الجسم للرّصاص بنسب عالية قد يؤدّي ذلك إلى حدوث ضعف في عملية إنتاج كريات الدم الحمراء، وبالتالي الإصابة بفقر الدم.
فقر الدم الحديدي (الأرومات) (بالإنجليزية: Sideroblastic anemia) هو مجموعة من اضطرابات الدم التي تتمثّل بعدم قدرة الجسم على استخدام الحديد بشكل صحيح لتصنيع الهيموجلوبين، على الرغم من وجود الحديد في الجسم بكميات كافية، نتيجة لذلك، يتراكم الحديد في خلايا الدم الحمراء، فيظهر ما يُعرف بالأرومة الحلقية (بالإنجليزية: Ringed sideroblast)، التي تحدث عند وجود خلل في قدرة نخاع العظم على إنتاج كريات دم حمراء طبيعية، وتجدر الإشارة إلى وجود العديد من الأسباب التي قد تكمن وراء الإصابة بهذا النوع من فقر الدم؛ والتي يمكن أن تكون مجهولة السبب، أو وراثية أو مكتسبة كاستخدام بعض أنواع الأدوية أو التعرض لبعض المواد الكيميائية السامة.[١٠]
قد يحدث فقر الدم بسبب الإصابة بمرض حوض البحر الأبيض المتوسط أو كما يُسمى بالثلاسيميا (بالإنجليزية: Thalassemia) وهو من الاضطرابات الوراثية التي قد تنتج بسبب وجود طفرات في الحمض النووي المسؤول عن تصنيع الهيموغلوبين وكريات الدم الحمراء، ممّا يؤثّر في إنتاج ما يكفي من كريات الدم الحمراء الطبيعية، وبالتالي عدم حصول الجسم على ما يكفي من الأكسجين، ويجدر بيان أنّ الهيموجلوبين يتكون من أربعة سلاسل بروتينية، سلسلتين من النوع ألفا وسلسلتي بيتا، وبناءً على ذلك يمكن تقسيم الثلاسيميا إلى شكلين وفقاً لنوع السلاسل المتأثرة فيها؛ حيث يُعرف الأول بثلاسيميا ألفا (بالإنجليزية: Alpha-thalassemia)، وتعتمد شدّة المرض فيه على عدد الطفرات الجينية التي حدثت، في حين أنّ الثاني يسمّى بثلاسيميا بيتا (بالإنجليزية: Beta-thalassemia) الذي تعتمد شدّة المرض فيه على الجزء المتأثّر من الهيموغلوبين بالطفرات.[١١]
فقر دم الأمراض المزمنة (بالإنجليزية : Anemia of chronic disease) هو فقر الدم الذي ينتج بسبب الإصابة ببعض الأمراض المزمنة، مثل: السرطان، والتهاب المفاصل الروماتويدي، وداء كرون، والعديد من الأمراض المزمنة التي قد تؤثر على إنتاج كريات الدم الحمراء.[١٢]
كما يُعتبر فقر الدم المرتبط بمرض الكلى المزمن (بالإنجليزية: Anemia related to kidney disease) أحد أنواع فقر الدم التي تحدث عندما تعجز الكلى عن أداء وظائفها بشكل دائم، ففي الوضع الطبيعي تفرز الكليتين هرمون إريثروبويتين والذي يُحفز نخاع العظم على تصنيع كريات الدم الحمراء، وفي حال فقدان الكليتين القدرة على العمل بكفاءة، فقد يحدث فقر الدم الذي قد يبدأ في المراحل المبكرة من الإصابة بمرض الكلى المزمن، أي عندما تكون وظائف الكلى طبيعية بنسبة 20-50%، ويُشار إلى أنّ فقر الدم قد يزداد سوءًا مع تفاقم مرض الكل المزمن وتطوره، ويتم التحكم بهذا النوع من فقر الدم من خلال استخدام الأشكال الدوائية المصنعة من هرمون إريثروبويتين.[٥][١٣]
يحدث فقر الدم الانحلالي (بالإنجليزية: Hemolytic Anemia) في حال كان معدل تحلّل كريات الدم الحمراء أكبر من معدل إنتاج كريات جديدة، ولفهم هذا السياق بصورة أفضل، يجدر بيان أنّه وفي الوضع الطبيعي يتخلّص الجسم من كريات الدم القديمة والتالفة كل 120 يومًا، وذلك عن طريق الطحال وأجزاء أخرى من الجسم بعملية تُعرف بانحلال الدّم (بالإنجليزية: Hemolysis)، ولكن في بعض الحالات قد تزداد سرعة تحلل هذه الكريات فتتحطم في الجسم خلال فترة زمنية أقل من ذلك، كما في حال الإصابة باضطرابات المناعة الذاتية؛ حيث يتعرّف الجهاز المناعي في الجسم على كريات الدم الحمراء بالخطأ على أنّها مواد غريبة ويجب التخلص منها فيهاجمها، بالإضافة إلى وجود بعض الحالات والاضطرابات الصحية الأخرى، مثل: الإصابة بمرض الثلاسيميا أو مرض فقر الدم المنجلي، أو الإصابة بارتفاع شديد في ضغط الدم، أو الإصابة بعدوى ما، أو حدوث فشل في نخاع العظم، وغيرها.[١٤][١٥]
قد يحدث فقر الدم بسبب التعرض لإصابة ما أدت إلى حدوث نزيف لفترة طويلة، مثل: الخضوع للجراحة أو الولادة أو حدوث إصابة أدت لتمزق الأوعية الدموية، أو الإصابة بقرحات في المعدة والأمعاء الدقيقة، والأورام الحميدة والخبيثة في الأمعاء الغليظة والكلى والمثانة، مما يؤدي لفقدان كميات من الدم وما يحمله من كريات الدم الحمراء، وبالتالي ستقل كمية الأكسجين المنقولة لخلايا الجسم بسبب انخفاض عدد كريات الدم الحمراء، وبالرغم من أن نخاع العظم ينتج كريات دم حمراء جديدة لتعويض الكميات المفقودة، إلا أنه ومع استمرار النزيف قد لا يكون الإنتاج كافياً لتعويض المفقود، كما قد يتم استنزاف كمية الحديد الموجودة في الجسم كما أسلفنا، وبالتالي لن يتمكن نخاع العظم من تعويض المفقود من الدم، وبالتالي يجب أن يُعالج السبب الذي أدى للنزيف، وقد يكون هناك داعي لعمليات نقل الدم وتناول المكملات التي تحوي على الحديد إذا أشار الطبيب لضرورة ذلك.[١٦][١٧]
الهوامش (*) داء كرون: مريض التهابي مزمن يصيب الجهاز الهضمي يتسبّب بظهور العديد من الأعراض، كآلام البطن، والإسهال المزمن والذي قد يصاحبه خروج دم مع البراز، وفقدان الوزن، وغير ذلك.[١٨]
(*) الخلايا الجذعية: هي خلايا غير متخصّصة لها القدرة على التمايز إلى أنواع مختلفة من الخلايا، وكذلك لها القدرة على الانقسام وإنتاج خلايا من النوع نفسه، وهي على شكلين؛ الخلايا الجذعية الجنينية، والخلايا الجذعية البالغة.[١٩]
(*) أكسيد النيتروز: هو غاز عديم اللون والرائحة، قد يستخدم في العيادات الطبية وعيادات طب الأسنان كمسكن في حالات الألم الخفيفة، ويمكن أن يقلل من القلق، كما أنّه يسبّب حدوث نشوة عند إساءة استخدامه.[٢٠]
(*) العامل الداخلي: هو بروتين ينتج بواسطة خلايا جدرار المعدة، ويساعد على امتصاص فيتامين ب 12، وإنّ وجوده في الجسم بكميات غير كافية يؤدّي إلى حدوث فقر الدم الخبيث.[٢١]
شاهد الفيديو لتعرف ما هي أسباب فقر الدم :
- ↑ “Red Blood Cell Production”, www.msdmanuals.com, Retrieved 9-11-2019. Edited.
- ↑ “All you need to know about bone marrow”, www.medicalnewstoday.com, Retrieved 9-11-2019.
- ^ أ ب ت ث ج “Anemia”, www.webmd.com, Retrieved 9-11-2019. Edited.
- ↑ “Iron deficiency anemia”, www.mayoclinic.org, Retrieved 7-11-2019. Edited.
- ^ أ ب “Anemia”, www.emedicinehealth.com, Retrieved 7-11-2019. Edited.
- ↑ “Vitamin B12 deficiency anemia”, medlineplus.gov, Retrieved 8-11-2019. Edited.
- ↑ “Folate-deficiency anemia”, medlineplus.gov, Retrieved 8-11-2019. Edited.
- ↑ “Sickle Cell Disease”, www.medlineplus.gov, Retrieved 7-11-2019. Edited.
- ↑ “Aplastic Anemia & Myelodysplastic Syndromes”, www.niddk.nih.gov, Retrieved 7-11-2019. Edited.
- ↑ “Sideroblastic anemia”, www.rarediseases.info.nih.gov, Retrieved 28-11-2019.
- ↑ “Thalassemia”, www.mayoclinic.org, Retrieved 8-11-2019. Edited.
- ↑ “Anemia”, www.mayoclinic.org, Retrieved 27-11-2019.
- ↑ “Anemia in Chronic Kidney Disease”, www.niddk.nih.gov, Retrieved 8-11-2019. Edited.
- ↑ “Everything you need to know about anemia”, medicalnewstoday, Retrieved 7-11-2019. Edited.
- ↑ “Hemolytic Anemia”, www.nhlbi.nih.gov, Retrieved 8-11-2019. Edited.
- ↑ “Etiology of Anemia”, www.msdmanuals.com, Retrieved 9-11-2019. Edited.
- ↑ “Anemia Due to Excessive Bleeding”, www.msdmanuals.com, Retrieved 9-11-2019. Edited.
- ↑ “Crohn’s Disease”, www.webmd.com, Retrieved 1-12-2019. Edited.
- ↑ “Stem Cells”, www.medlineplus.gov, Retrieved 1-12-2019. Edited.
- ↑ “What to know about nitrous oxide”, www.medicalnewstoday.com, Retrieved 28-11-2019.
- ↑ “Intrinsic factor”, www.medlineplus.gov, Retrieved 28-11-2019. Edited.